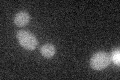
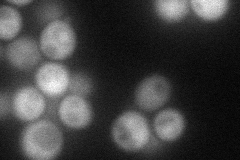
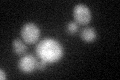
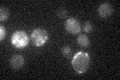

View description
Transcriptional repressor involved in response to pH and in cell wall construction; required for alkaline pH-stimulated haploid invasive growth and sporulation; activated by proteolytic processing; similar to A. nidulans PacC
Localization:
Intensity:
Fold change:
Significance:
-
C’ GFP library in SD
below threshold16.48 -
N' NOP1pr-GFP in SD
cytosol64.6882 -
N' TEF2pr-mCherry in SD

below threshold20.3525 -
N' NATIVEpr-GFP in SD

nucleus45.1705 -
N' TEF2pr-VC and Cyto-VN in SD

#N/A0 -
C’ GFP library in SD+DTT
cytosol16.40.99No -
C’ GFP library in SD+H2O2

cytosol18.711.13No -
C’ GFP library in Starvation Media
cytosol16.81.01No -
C’ GFP library on the background of Pup2-DaMP

below threshold -
C’ GFP library on the background of CCT mutant

below threshold16.62561.00796No
